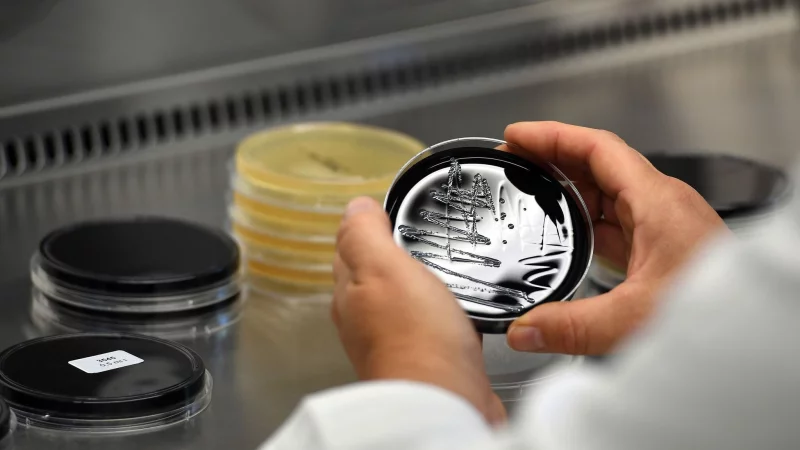
Werden Legionellen im Trinkwasser festgestellt, sind die Kosten f&uuml;r die Ursachenforschung und die Beseitigung des Befalls in der Regel vom Vermieter zu tragen. - &copy; Federico Gambarini/dpa/dpa-tmn

Vermieter sind dazu verpflichtet, alle drei Jahre die Warmwasserversorgungen auf Legionellen prüfen zu lassen. «Der Untersuchungspflicht unterliegen nahezu alle Anlagen in Gebäuden mit einer zentralen Warmwasserversorgungsanlage», sagt Dr. Jutta Hartmann vom Deutschen Mieterbund (DMB). «Nur für Ein- und Zweifamilienhäuser gilt diese gesetzliche Pflicht nicht.» Die Ergebnisse müssen Vermieter ihren Mietern bekanntgeben und über mögliche Gesundheitsgefährdungen informieren.
Auch Mieter haben Pflichten
Damit eine solche Untersuchung möglich ist, müssen Mieter diese dulden - sprich, «dem Vermieter den dafür notwendigen Zutritt in die Mietwohnung gestatten», so Hartmann.
Besteht eine deutlich überhöhte Legionellenkonzentration, dürfen Bewohner ihre Miete um 20 bis 25 Prozent mindern, sagt Hartmann. Bei einer nur geringfügigen und kurzzeitigen Überschreitung der Grenzwerte ist eine Mietminderung dagegen nicht gerechtfertigt, so die Mietrechts-Expertin.
Wer übernimmt die Kosten?
Es kommt darauf an, ob es um eine allgemeine Prüfung oder die konkrete Beseitigung eines Befalls geht. «Die Kosten der regelmäßig durchzuführenden Legionellenprüfung sind Betriebskosten», sagt Hartmann. Vermieter können diese also als Teil der Warmwasserkosten auf die Mieter umlegen.
«Werden Legionellen im Trinkwasser festgestellt, so sind die Kosten für die Ursachenforschung und die Beseitigung des Befalls in der Regel vom Vermieter zu tragen», sagt die Juristin. Hier ginge es um Kosten aus einem konkreten Schadensfall, «die mithin nicht laufend anfallen und daher nicht umlagefähig sind.»
Um die Leitungen zu reinigen, wird das Wasser kurzfristig stark erhitzt. Auch die Wasser- und Erwärmungskosten für die Durchführung der thermischen Desinfektion müssen Hartmann zufolge bei der jährlichen Warm- und Kaltwasser-Abrechnung abgezogen werden - notfalls als Schätzung.
Legionellen - nach dem Urlaub erhöhte Gesundheitsgefahr
Legionellen findet man weltweit in Wasserleitungen in Gebäuden. Die Erreger vermehren sich in künstlichen Wassersystemen am besten bei Temperaturen zwischen 25 Grad Celsius und 45 Grad Celsius, heißt es auf dem Portal «infektionsschutz.de» des Bundesinstituts für Öffentliche Gesundheit (BIÖG). Bei Temperaturen oberhalb von 60 Grad Celsius sterben sie ab. Unterhalb von 20 Grad Celsius vermehren sie sich kaum noch.
Die Bakterien können eine schwere Form der Lungenentzündung oder das Pontiac-Fieber auslösen - besonders für immunschwache Menschen und Schwangere eine Gefahr. Übertragen werden die Erreger laut BIÖG durch fein zerstäubtes Wasser. Diese sogenannten Aerosole können sich in der Luft verbreiten und dann eingeatmet werden. Eine Übertragung beim Trinken gilt als unwahrscheinlich.
Wichtig zu wissen: Wenn durch die Leitung längere Zeit kein Wasser läuft, kann das die Vermehrung von Legionellen begünstigen. Wenn sich die Keime stark verbreiten, erhöht dies das Gesundheitsrisiko. Daher sollte man nach einem Urlaub oder längeren Abwesenheiten das Wasser immer erst mehrere Minuten laufenlassen, rät die Prüfanstalt Dekra. Das sei wichtig, damit die Leitungen durchgespült und das stehende Wasser durch frisches ersetzt wird.